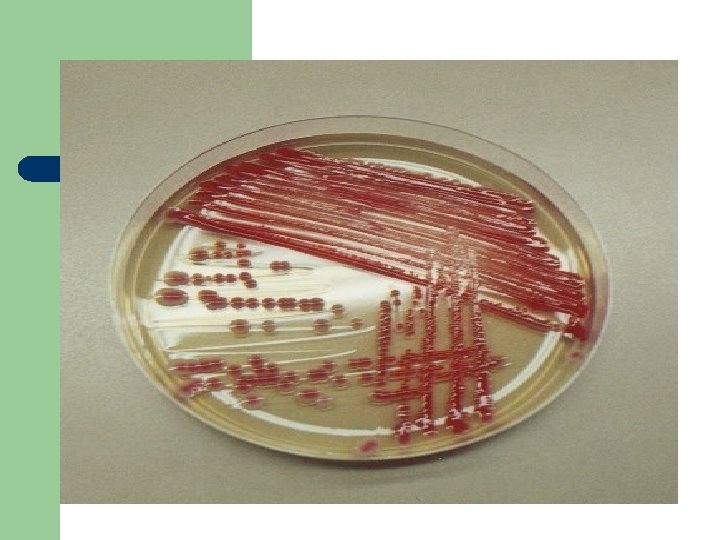
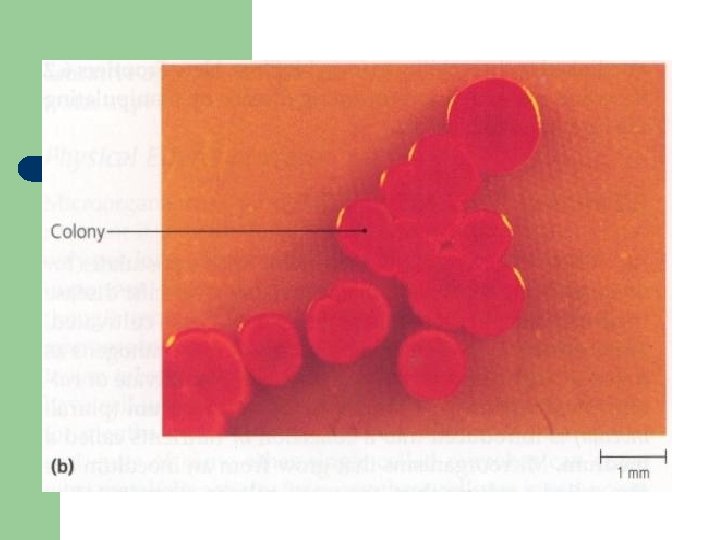
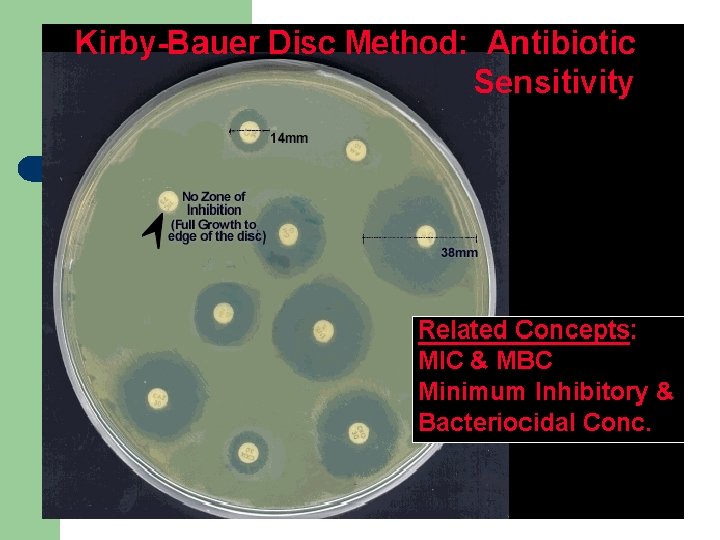

ROSLAILI RASYID Mikroorganisme PROKARYOTIC vs EUKARYOTIC STRUCTURE PROKARYOTIC

- Slides: 57
ROSLAILI RASYID
Mikroorganisme
PROKARYOTIC vs EUKARYOTIC STRUCTURE PROKARYOTIC CELL: Bacteria, EUKARYOTIC CELL: Protozoa, Fungi
l Bakteri adalah mikroorganisme prokaryot yaitu organisme yang materi intinya tidak terbungkus oleh membran.
Taxonomy Domain l Kingdom l Phylum l Class l Order l Family l Genus l species (Bergey’s Manual of Determinative Bacteriologi)
Classification Systems in the Procaryotae 1. 2. 3. 4. 5. 6. Microscopic morphology Macroscopic morphology – colony appearance Physiological / biochemical characteristics Chemical analysis Serological analysis Genetic and molecular analysis
Micoorganisms l l Binomial (scientific) nomenclature Gives each microbe 2 names: – – l Genus - noun, always capitalized species - adjective, lowercase Both italicized or underlined – – – Staphylococcus aureus (S. aureus) Bacillus subtilis (B. subtilis) Escherichia coli (E. coli)
Morfologi bakteri
• Diplococcus : Neisseria gonorhoe Neisseria meningitidis
Streptococcus sp
Staphylococcus aureus
Mycobacterium tuberculosis
Haemophillus influenzae
Vibrio cholera : bentuk koma (batang bengkok/melengkung)
Spirochaeta
Leptospira
1. 2. 3. 4. 5. 6. 7. 8. 9. Dinding sel Membran sitoplasma Ribosom Intisel Flagel Kapsul/simpai Fimbriae/pili Granula Spora
Prokariotik
Dinding sel bakteri l l Fungsi : Perbedaan dinding sel bakteri Gram positif dengan bakteri Gram negatif :
Flagel Fungsi : Ada 4 macam: 1. Monotrich 2. Amphitrich 3. Lofotrich 4. Peritrich
Flagel lofotrich
Flagel monotrich
Fimbriae/pili l l Fungsi : Pili F , gunanya:
Fimbriae =pili
Kapsul /simpai /envelope l l Fungsinya ; Reaksi Quellung :
Kapsul (simpai/envelope) bakteri
Klebsiella sp
Spora / endospora l l l Bakteri yang dapat membentuk spora : -Clostridium -Bacillus Spora terbentuk pada keadaan : proses sporulasi & germinasi Letak spora : sentral, subterminal, terminal
Spora Clostridium tetani terminal
Endospore Production
Granula l Kuman yang memiliki granul sebagai cadangan makanan : - Mycobacterium tuberculosis - Corynebacterium diphteriae
Granula metachromatic pada kuman Corynebacterium diphteriae
Reproduksi bakteri l l Aseksual umumnya membelah secara amitosis, menjadi 2 bagian (binary division). generation time umumnya 15 -20 menit (kecuali M. tuberculosis: 15 - 20 jam) Seksual : peleburan kromosom 2 bakteri yang sejenis melalui pili F (pili sex)
Pembelahan kuman : binary division
Cell division What is happening?
Reproduksi bakteri
SUBSTANSI YANG UMUM DIPERLUKAN A. B. C. D. E. F. G. AIR GARAM –GARAM ANORGANIK MINERAL FAKTOR PERTUMBUHAN OKSIGEN SUHU p. H
oksigen -aerob obligat; -anaerob fakultatif; -aneerob aerotolerans -mikroaerofilik;
OXYGEN REQUIREMENT
Suhu -psikhrofilik; opt 10 -20 C -mesofilik ; opt 20 -40 C -termofilik; opt >40 C p. H ; opt 7, 2 – 7, 6
Phases of bacterial growth Log of numbers of bacteria Log growth phase Stationary phase Death phase Lag phase 0 5 Time (hr) 10
1. Fase Penyesuaian diri (lag phase) -kuman belum berkembang biak -aktivitas metabolik meningkat 2. Fase Pembelahan (log/exponential phase) -jumlah kuman meningkat secara eksponensial -fase ini dapat dipertahankan dengan alat; Kemostat & Turbidostat 3. Fase stasioner (stationary phase) -jumlah kuman yang mati dg membelah seimbang 4. Fase kemunduran (period of decline), death phase -muncul bentuk involusi
Identifikasi koloni kuman